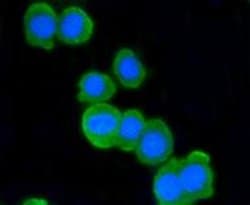
Invitrogen ATM Recombinant Rabbit Monoclonal Antibody (SI70-01) 100 &mu;L | Buy Online | Invitrogen&trade; | Fisher Scientific

Läs mer
Invitrogen™ ATM Recombinant Rabbit Monoclonal Antibody (SI70-01)
Beskrivning
Recombinant rabbit monoclonal antibodies are produced using in vitro expression systems. The expression systems are developed by cloning in the specific antibody DNA sequences from immunoreactive rabbits. Then, individual clones are screened to select the best candidates for production. The advantages of using recombinant rabbit monoclonal antibodies include: better specificity and sensitivity, lot-to-lot consistency, animal origin-free formulations, and broader immunoreactivity to diverse targets due to larger rabbit immune repertoire.

Specifikationer
Specifikationer
| Antigen | ATM |
| Användningsområden | Immunohistochemistry (Paraffin), Western Blot, Immunocytochemistry, Western Blot |
| Klassificering | Recombinant Monoclonal |
| Klona | SI70-01 |
| Koncentration | 1 mg/mL |
| Konjugera | Unconjugated |
| Formulering | TBS with 40% Glycerol, 0.05% BSA and 0.05% sodium azide; pH 7.4 |
| Gen | ATM |
| Genaccessionsnr. | Q13315 |
| Gene Alias | AI256621; AT mutated; A-T mutated; A-T mutated homolog; AT mutated protein; AT1; ATA; Ataxia t; Ataxia telangiectasia gene mutated in human beings; ataxia telangiectasia mutated; Ataxia telangiectasia mutated homolog; ATC; ATD; ATDC; ATE; Atm; ATM serine/threonine kinase; C030026E19Rik; DKFZp781A0353; EC 2.7.1.37; MGC74674; serine-protein kinase ATM; TEL1; TEL1, telomere maintenance 1, homolog; TELO1 |
| Visa mer |
Genom att klicka på Skicka bekräftar du att du kan bli kontaktad av Fisher Scientific angående feedbacken du har lämnat i detta formulär. Vi kommer inte att dela din information för andra ändamål. All kontaktinformation som tillhandahålls ska också underhållas i enlighet med vår Sekretesspolicy.